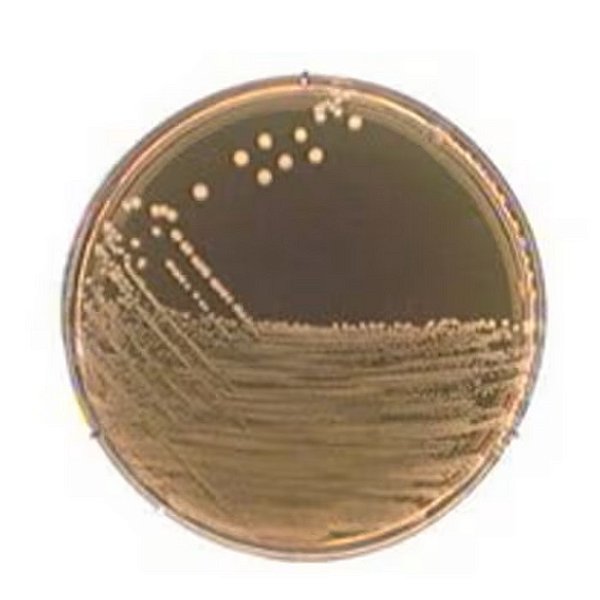
ÁGAR M-17 - 500g - Merck
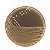
ÁGAR M-17 - 500g - Merck - Imagem 1

-
- 1x de R$ 1.300,90 sem juros
- 2x de R$ 650,45 sem juros
- 3x de R$ 433,63 sem juros
- 4x de R$ 325,22 sem juros
- 5x de R$ 260,18 sem juros
- 6x de R$ 216,81 sem juros
-
- 1x de R$ 1.300,90 sem juros
- 2x de R$ 713,15
- 3x de R$ 482,33
-
R$ 1.300,90

M-17 Ágar, NutriSelect® Basic, em pó, para Lactococcus spp., para Streptococcus spp., embalagem de 500 g
Aplicação:
O meio M-17 Agar é recomendado para o cultivo, detecção e contagem de estreptococos lácticos no leite e produtos lácteos. O meio M-17 é superior a outros meios de cultura comparáveis para o cultivo das espécies exigentes Streptococcus cremoris, Streptococcus diacetilactis e Streptococcus Iactis. Também é adequado para o cultivo e manutenção de culturas iniciadoras para a fabricação de queijo e iogurte. Este meio ajuda na detecção de mutantes estreptocócicos que não fermentam lactose. O meio ágar M-17 também pode ser usado para a diferenciação de bacteriófagos que infectam estreptococos lácticos.
Propriedades:
Esterilidade: Não esterilizado
Forma: Pó
Prazo de validade: Limitado, data de validade indicada no rótulo
Composição: ágar, 12,75 g/L ; ácido ascórbico, 0,5 g/L ; peptona de caseína (tripsina), 2,5 g/L ; ²-glicerofosfato dissódico pentahidratado, 19 g/L ; sulfato de magnésio hidratado, 0,25 g/L ; extrato de carne, 5 g/L ; peptona de carne (pepática), 2,5 g/L ; peptona de soja (papaínica), 5 g/L ; extrato de levedura, 2,5 g/L
Produto: Embalagem com 500g
pH final: 7.1±0.2 (25 °C)
Adequação: Lactococcus spp. ; Streptococcus spp.
Produtos relacionados
- Fale Conosco
- Meios de Cultura para Laboratório: Da Descoberta à Utilização nos Dias Atuais
- PLACA DE PÉTRI: HISTÓRIA E APLICAÇÃO ATUAL.
- Política de privacidade
- Política de Trocas e Devoluções
- Quem somos
- Vidrarias de Laboratório: Conheça as Funções e a Importância dos Frascos Reagentes de Vidro Borossil
A Petri Lab é uma loja completa para equipar o seu laboratório com equipamentos e consumíveis de qualidade. Encontre tudo que precisa para pesquisa e análises com preços competitivos e entrega rápida para todo o Brasil.